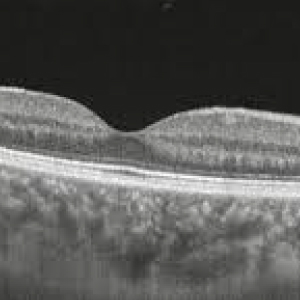

Rétine et vitré
Diagnostics avancés pour protéger la santé de votre rétine.

La rétine est la partie de l’œil qui nous permet d’identifier les objets. Il est responsable de la transformation des impulsions lumineuses en signaux nerveux et de leur envoi au cerveau via le nerf optique.
Quant au vitré, il s’agit d’une substance visqueuse et incolore située entre le cristallin et la rétine elle-même.
Les différentes pathologies (cliquez pour y accéder) :

Que vos souvenirs ne s'effacent pas avec le temps
Dégénérescence maculaire liée à l’âge

La vitesse et la fiabilité dont vos yeux ont besoin
Décollement de la rétine

Votre vision sans distraction

Une approche globale améliore le contrôle de l'uvéite
Uvéite

Un diagnostic précoce pour protéger votre vision contre le diabète
Rétinopathie diabétique

Nous redonnons de la clarté à votre vision
Trou maculaire

Il semble que votre vision mérite une seconde chance
Thrombose de la veine rétinienne

Vos yeux, à l'abri des dangers de la forte myopie
Forte myopie

Parce que la vie mérite toute notre attention.
Rétinite pigmentaire
Chaque détail mérite d'être vu clairement.
Membrane épirétinienne maculaire

Technologie de pointe pour l'évaluation et le suivi des tumeurs oculaires
Tumeurs intraoculaires
Assureurs et mutuelles d’assurance
Assureurs et mutuelles d’assurance






















































Voici quelques-unes des mutuelles et des assureurs maladie avec lesquels nous collaborons. Cependant, l’accord avec ces mutuelles dépend du centre de santé.
Si votre police n’apparaît pas dans la liste, n’hésitez pas à nous contacter pour plus d’informations.
Anna Casas30/06/2025Trustindex verifica que la fuente original de la reseña sea Google. Me operé el 17/6 y estoy contentísima. Empezando por Judith, la recepcionista que tuvo conmigo una paciencia alucinante (si lees esto, gracias) y siguiendo con la doctora Saskia, como siempre tan cercana como profesional, explicandomelo todo y haciéndome sentir tranquila. Ella me explicó la operación en su día, decidí hacérmela y a día de hoy no puedo estar más contenta con su profesionalidad. Todas las mujeres que estuvieron en quirófano ese día, excelentes profesionales, lamento no haber preguntado sus nombres, me hicierion sentir muy cómoda y eso que venía nerviosa. Yolanda Martinez15/04/2025Trustindex verifica que la fuente original de la reseña sea Google. Fantástica, la Dra.Romero es una gran profesional, ojalá fueran tod@s como ella MARILYN CALENDA19/03/2025Trustindex verifica que la fuente original de la reseña sea Google. He acudido al doctor Maisterrena para una cirugía de un quiste y su atención ha sido muy buena, delicado con su trabajo Jesús María Ramírez Duval08/03/2025Trustindex verifica que la fuente original de la reseña sea Google. Las visitas suelen tardar de la hora reservada, pero es normal. Están con los pacientes el tiempo necesario para dar buen servicio. Antonio Mula Vallejo06/03/2025Trustindex verifica que la fuente original de la reseña sea Google. Muy bien atendido S V26/02/2025Trustindex verifica que la fuente original de la reseña sea Google. Great experience. I was received promptly and the staff as well as Dra. Marin were excellent. She took care and time to explain the outcome of the consultation and the different treatment options -- a rare luxury in healthcare these days. Thrilled to have found this practice. enric robledo14/02/2025Trustindex verifica que la fuente original de la reseña sea Google. María Andrea Cantore Aldasoro31/01/2025Trustindex verifica que la fuente original de la reseña sea Google. Acudí al doctor Maisterrena por recomendación y la experiencia no podría haber sido mejor. Desde el primer momento, me informó con todo detalle, demostrando una gran profesionalidad, seriedad y rigor. Los procedimientos que me realizó requieren una altísima especialización, y en todo momento me transmitió absoluta confianza. Su precisión y cuidado son impecables. Sin duda, un profesional de primer nivel. Rosa Maria Gil18/01/2025Trustindex verifica que la fuente original de la reseña sea Google. Sofia Vitucci22/12/2024Trustindex verifica que la fuente original de la reseña sea Google. Excelente trato por parte del Dr Maisterrena. Me hice un tratamiento estético: él escucha tus necesidades y te aconseja lo mejor!La evaluación general en Google es 4.2 de 5, en base a 58 reseñas